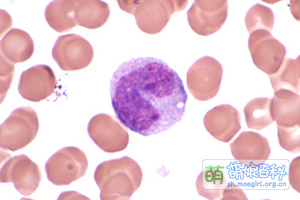

萌娘百科不提供医学建议。
萌娘百科条目中的现实医学相关内容仅供参考,不能作为专业意见。如有需要,请咨询医学专业人士。萌娘百科对条目内可能错误的信息不承担任何责任。
如发现任何条目有刻意宣传现实药物、疗法或医疗机构等内容,请及时到萌娘百科 talk:讨论版/页面相关举报。
萌娘百科条目中的现实医学相关内容仅供参考,不能作为专业意见。如有需要,请咨询医学专业人士。萌娘百科对条目内可能错误的信息不承担任何责任。
如发现任何条目有刻意宣传现实药物、疗法或医疗机构等内容,请及时到萌娘百科 talk:讨论版/页面相关举报。
基本资料
本名
单核细胞(単球( ))
别号
发色
不可见棕
瞳色
不可见棕
出身地区
骨髓
活动范围
血液
个人状态
在脾脏中待命/在血液中巡逻
亲属或相关人
单核细胞(日文:
人体中的单核细胞
单核细胞是体积最大的白细胞,直径约14~20μm,来自骨髓;它可以分化成巨噬细胞或常规树突状细胞。单核细胞是后天免疫系统的重要组成部分之一,核呈肾型,马蹄铁形或扭曲折叠的不规则形,胞质丰富,弱嗜碱性,内含许多细小的嗜天青颗粒,即溶酶体,主要职责和巨噬细胞有所重叠:吞噬抗体,提呈抗原,和分泌细胞因子/白细胞介素。在有炎症信号时,在病灶快速补充巨噬细胞和树突状细胞也是单核细胞的重要工作。
来源和职责
单核细胞由骨髓中的成单核细胞(英语:Monoblast,一种双能祖细胞)分化而成;究其源头,成单核细胞分化自大名鼎鼎的造血干细胞。单核细胞随血液在人体中循环约莫12~48h;之后,它们通常会进入组织中,然后分化为巨噬细胞或树突状细胞。单核细胞大约占所有白细胞的百分之3至8。 成年人的脾脏保有人体约莫一半的单核细胞[1]。
单核细胞和巨噬细胞相似,也可以吞噬病原体;单核细胞还可以利用ADCC作用(抗体依赖的细胞介导(媒介)的细胞毒性作用)摧毁被感染的目标(例如一般细胞)。
以下细胞均由单核细胞分化且具有强大的吞噬能力,与单核细胞一起称为单核吞噬细胞系统
- 巨噬细胞
- 骨组织的破骨细胞
- 神经组织的小胶质细胞
- 肝巨噬细胞(库普夫细胞)
- 肺巨噬细胞(尘细胞)
工作中的单核细胞
经历
| ||||||||||||||||||||||||||||||||||||||||||||||||||||||||||
注释与外部链接
- ↑ Swirski, FK; Nahrendorf, M; Etzrodt, M; Wildgruber, M; Cortez-Retamozo, V; Panizzi, P; Figueiredo, J-L; Kohler, RH; Chudnovskiy, A; Waterman, P; Aikawa, E; Mempel, TR; Libby, P; Weissleder, R; Pittet, MJ. Identification of Splenic Reservoir Monocytes and Their Deployment to Inflammatory Sites. Science. 2009, 325 (5940): 612–616. PMC 2803111. PMID 19644120. doi:10.1126/science.1175202.


